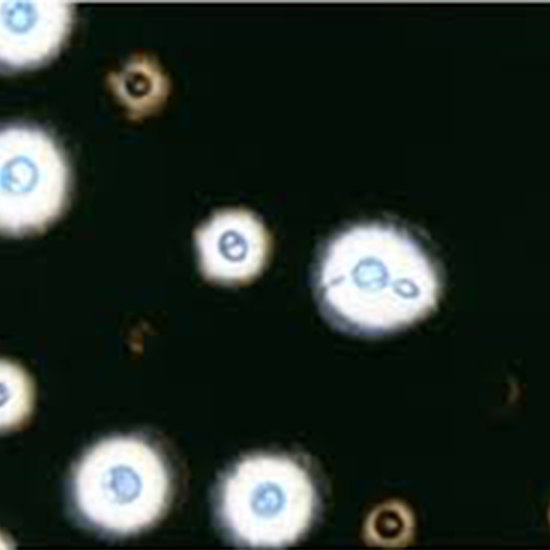

Book Cryptococcus Antigen CSF Appointment Online Near me at the best price in Delhi/NCR from Ganesh Diagnostic. NABL & NABH Accredited Diagnostic centre and Pathology lab in Delhi offering a wide range of Radiology & Pathology tests. Get Free Ambulance & Free Home Sample collection. 24X7 Hour Open. Call Now at 011-47-444-444 to Book your Cryptococcus Antigen CSF at 50% Discount.
The Cryptococcus antigen test is used to determine whether or not a person has a Cryptococcus neoformans fungus infection. The lungs, brain, and central nervous system are the primary targets. Cryptococcosis is frequent in immune-compromised persons with HIV/AIDS or those using immunosuppressive medications.
The fungus Cryptococcus neoformans attacks the brain system and the lungs. Therefore, the test is the most effective diagnostic approach for an early diagnosis of Cryptococcal infection.
The Cryptococcus antigen test aids in the early detection of the problem before it progresses to cryptococcal meningitis, which can be fatal if not treated. It is possible to detect Cryptococcus antigen in serum 22 days before the onset of meningitis symptoms using an antigen test performed on blood samples or cerebrospinal fluid. An elevated antigen titter implies the presence of an active infection.
An unintended weight loss, tiny red spots, swollen glands, unusual sweating, dry cough, fever, confusion, chest discomfort, impaired vision and nausea are signs of cryptococcosis. Other symptoms include weariness and fatigue-like symptoms, nausea and vomiting, and fatigue-like symptoms.
>>You'll have blood extracted from an arm vein.
>>No preparation is needed.
>>Leave the dressing strip on for 15 minutes. No particular type of care is required.
The Cryptococcus Antigen CSF Test cost varies by region and facility. So constantly get tested at trustworthy diagnostic centres like Ganesh Diagnostic. It is staffed by trained and experienced professionals to assure patient and visitor safety.
| Test Type | Cryptococcus Antigen CSF |
| Includes | Cryptococcus Antigen CSF Test (Neurology) |
| Preparation | |
| Reporting | Within 24 hours* |
| Test Price |
₹ 1600
|

Early check ups are always better than delayed ones. Safety, precaution & care is depicted from the several health checkups. Here, we present simple & comprehensive health packages for any kind of testing to ensure the early prescribed treatment to safeguard your health.